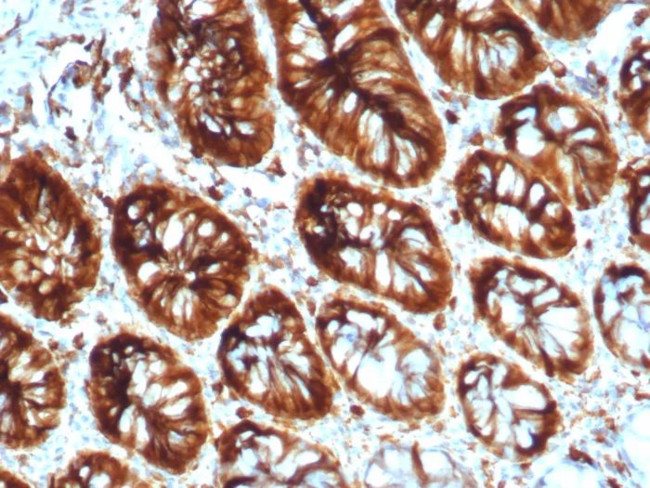
Stathmin 1/STMN1 Antibody in Immunohistochemistry (Paraffin) (IHC (P))
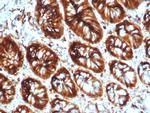
Stathmin 1/STMN1 Antibody in Immunohistochemistry (Paraffin) (IHC (P))

Search
NeoBiotechnologies
Stathmin 1/STMN1 Monoclonal Antibody (STMN1/8012)
{{$productOrderCtrl.translations['antibody.pdp.commerceCard.promotion.promotions']}}
{{$productOrderCtrl.translations['antibody.pdp.commerceCard.promotion.viewpromo']}}
{{$productOrderCtrl.translations['antibody.pdp.commerceCard.promotion.promocode']}}: {{promo.promoCode}} {{promo.promoTitle}} {{promo.promoDescription}}. {{$productOrderCtrl.translations['antibody.pdp.commerceCard.promotion.learnmore']}}
产品信息
3925-MSM2-P1
种属反应
宿主/亚型
分类
类型
克隆号
抗原
偶联物
形式
浓度
纯化类型
保存液
内含物
保存条件
运输条件
产品详细信息
Positive Control:Human brain or melanoma tissue.
Cellular Location: Cytoplasm. Cytoskeleton.
靶标信息
Stathmin 1 belongs to the stathmin family of genes. It encodes a ubiquitous cytosolic phosphoprotein proposed to function as an intracellular relay integrating regulatory signals of the cellular environment. Stathmin 1 is involved in the regulation of the microtubule filament system by destabilizing microtubules. It prevents assembly and promotes disassembly of microtubules. Multiple transcript variants encoding different isoforms have been found for this gene.
仅用于科研。不用于诊断过程。未经明确授权不得转售。
篇参考文献 (0)
生物信息学
蛋白别名: Leukemia-associated phosphoprotein p18; Metablastin; Oncoprotein 18; Op18; OTTHUMP00000008529; OTTHUMP00000008531; phosphoprotein 19; Phosphoprotein p19; pp17; pp19; Prosolin; Protein Pr22; RP1-125I3.5; Stathmin; stathmin 1 variant; stathmin 1/oncoprotein 18; STN1; testicular tissue protein Li 189; transmembrane protein C1orf215
基因别名: C1orf215; Lag; LAP18; OP18; PP17; PP19; PR22; SMN; STMN1
UniProt ID: (Human) P16949
Entrez Gene ID: (Human) 3925